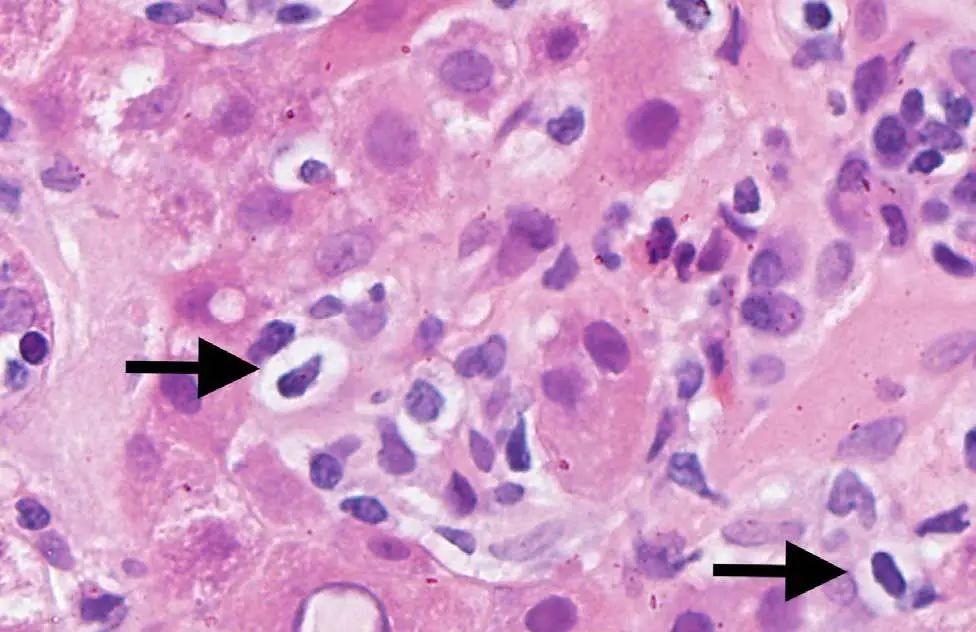
皮肤红疹有小水泡病例,病理性黄疸出现皮疹

病例介绍
患者,女,59岁,既往有血脂异常,因“皮肤和巩膜黄染2天”就诊。该患者在就诊前4周开始食欲不振,2周后右胸和背部出现水泡样改变,被诊断为带状疱疹。医生为其开具阿昔洛韦、头孢氨苄和非甾体抗炎药。经治疗后患者的带状疱疹有所改善,但持续食欲不振,并伴有间歇性餐后上腹痛。
患者无发热、腹痛、腹泻、关节痛或皮疹症状,已连续一年每天服用5 mg瑞舒伐他汀,并否认有其他药物使用、酒精摄入、生食摄入或输血史,自述有自身免疫性甲状腺炎家族病史。
体格检查发现右侧T3皮区有带痂的干燥小泡,巩膜黄染;未发现Kayser-Fleischer环,扑翼样震颤或弥漫性甲状腺肿。
实验室检查显示:白细胞计数正常,无嗜酸性粒细胞增多,但AST(683 U/L)、ALT(830 U/L)、总胆红素(7.62mg/dL)、直接胆红素(4.51mg/dL)、碱性磷酸酶(287 U/L)和γ谷氨酰转肽酶(165 U/L)均升高。
CT显示门静脉周围水肿伴有胆结石,无胆管扩张(图1)。

图1 CT示门静脉周围水肿伴胆结石
诊断有自身免疫性甲状腺炎伴甲状腺功能减退。表1提供了肝炎的详细实验室检查结果。
表1 急性肝炎的实验室检查

问题:这例患者的急性肝炎最可能由哪项病因导致?
A. 水痘-带状疱疹病毒性肝炎
B. 药物性肝损伤
C. 自身免疫性肝炎
D. 胆总管自发性穿孔后发生胆汁淤积性肝炎
答案
点击下方空白处获得答案
正确答案:C. 自身免疫性肝炎
患者已停用瑞舒伐他汀,但肝酶仍持续上升。患者治疗前的国际AIH评分为10,提示AIH的可能。
治疗
全身性糖皮质激素适用于ALT水平>10倍正常值上限的AIH患者,使用泼尼松龙60mg/d作为尝试性治疗。由于患者感染了带状疱疹,所以同时服用伐昔洛韦5天。
病理诊断
行肝活检,病理检查显示局灶性桥接或融合性坏死,伴有肝细胞脱落、凋亡(图2),易见成片浆细胞(图3)。

图2 患者病理切片示局灶性桥接或融合性坏死

图3 浆细胞团(箭头)
可见肝细胞玫瑰花环样结构(图4),淋巴浆细胞浸润和穿入现象(炎症活动时可见一个淋巴细胞进入和穿越另一个大淋巴细胞)(图5),但没有发现病毒包涵体,水痘-带状疱疹病毒(VZV)的PCR结果为阴性。

图4 肝细胞玫瑰花环结构(箭头)
图5 穿入现象
病理诊断提示AIH。
预后
接受糖皮质激素治疗后,患者的食欲和肝酶逐渐改善,治疗后的AIH评分为19,证实了AIH的诊断。患者的肝酶和IgG水平在3个月内恢复正常,但在泼尼松龙减量期间总胆红素和IgG再次升高(图6)。

图6 患者的ALT和总胆红素变化
总结
在免疫缺陷患者中通常观察到VZV感染,但其IgM抗体和VZV DNA应为阳性,故排除VZV感染性肝炎。
药物性肝损伤(DILI)患者的ALT水平升高通常是轻微的、无症状且自限性的,并且经常发生在治疗的3个月内。在糖皮质激素减量期间,肝酶也不会再次升高,故排除DILI。
AIH并不少见,但在自身抗体阴性的患者中,鉴别诊断较为困难。糖皮质激素一直是治疗急性AIH的主要方法,治疗后无应答者应重新考虑其他诊断。
9%-12%的DILI符合AIH的经典特征,并且对及时的糖皮质激素治疗有反应,所以很难区分这两种病因。关键是在AIH患者中,停用糖皮质激素后,肝酶可能会再次升高,但在DILI中不会观察到这一现象。
AIH与一些病毒(如HCV和EB病毒)感染有关。此例患者在VZV感染后立即发生血清反应阴性的AIH,表明由于病毒和宿主之间存在分子拟态(molecular mimicry),VZV感染可能引发自身免疫反应。
医脉通编译整理自:Chang KC, Tsai JH, Su TH. A mysterious case of jaundice after development of skin vesicles. Gastroenterology. 4 April 2020. https://doi.org/10.1053/j.gastro.2020.04.031